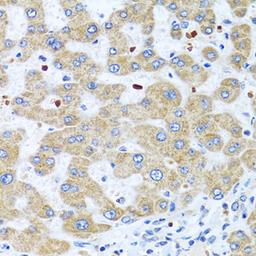
Immunohistochemistry - NMU antibody (A7068)

Product & ReviewsAntibodies
NMU Rabbit pAb
Product Details
- Cat. No.
- A7068
- Type
- Primary Antibody
- Clonality
- Polyclonal
- Host
- Rabbit

The supplier does not provide quotations for this antibody through SelectScience. You can search for similar antibodies in our Antibody Directory.
Description
This gene encodes a member of the neuromedin family of neuropeptides. The encoded protein is a precursor that is proteolytically processed to generate a biologically active neuropeptide that plays a role in pain, stress, immune-mediated inflammatory diseases and feeding regulation. Increased expression of this gene was observed in renal, pancreatic and lung cancers. Alternative splicing results in multiple transcript variants encoding different isoforms. Some of these isoforms may undergo similar processing to generate the mature peptide.
Biological Information
- Clonality: Polyclonal
- Host: Rabbit
- Reactivity: Human, Mouse